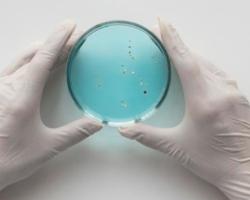
Legionella

El control de arañas no es una actividad tan habitual como el de cucarachas o roedores pero en ocasiones puede ser relevante conocer cuándo y cómo es necesario aplicar medidas de control frente a algunos arácnidos. Para ello, os recomendamos un nuevo trabajo de Mikel Alexander González y otros autores, en el que se dan a conocer la biología y medidas de control de Loxosceles rufescens, la única especie de araña de preocupación para la salud pública en España.
Notícias
Artículos destacados
Las garrapatas están ganando visibilidad como vectores de enfermedades, ya sea en estudios científicos, medios de comunicación o campañas institucionales. Sobre ellas nos habla Carlos Pradera, experimentado especialista en control de plagas urbanas en Anticimex, y aplicado estudioso de las garrapatas.